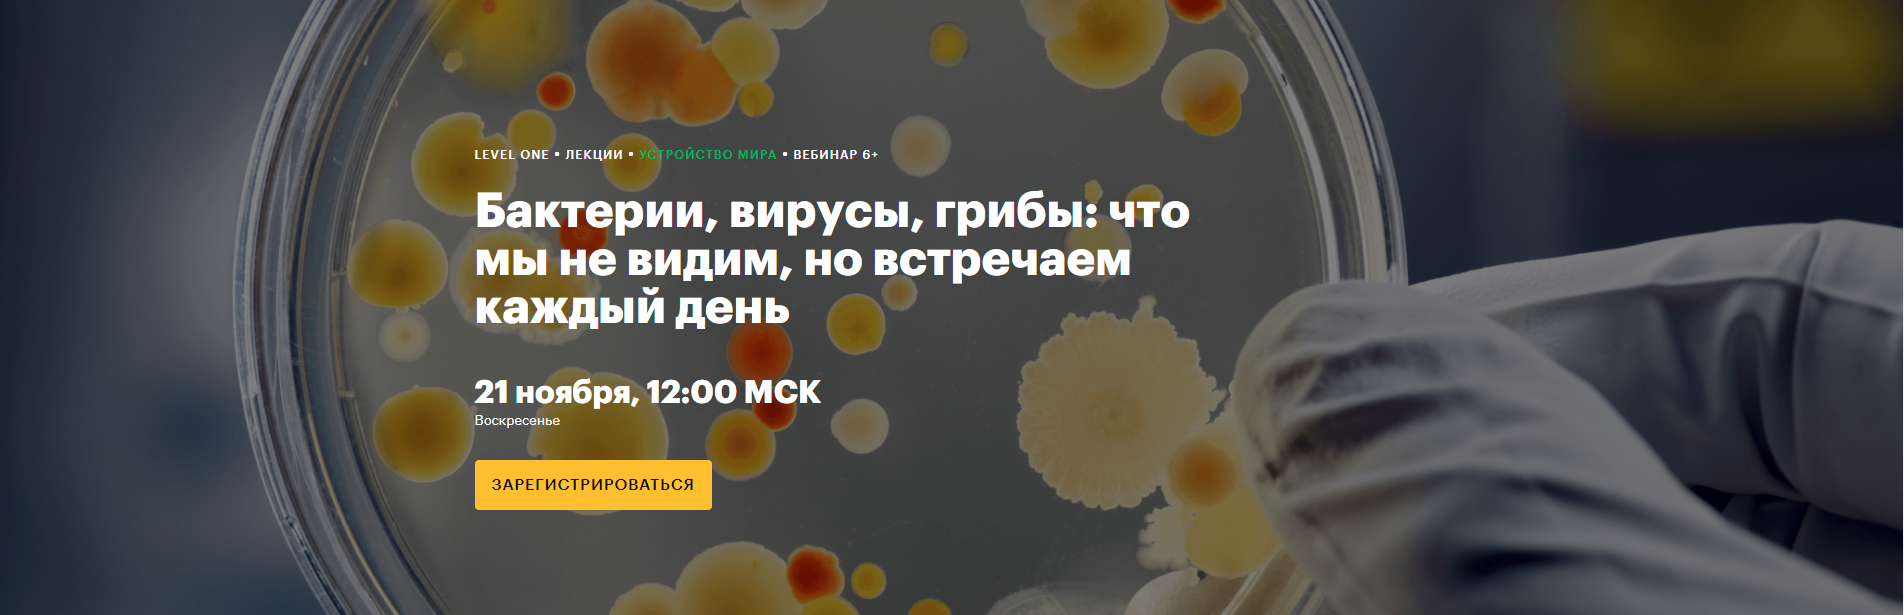
upload_2021-11-9_13-58-12.png

Голосов: 0
#1
Бактерии, вирусы, грибы: что мы не видим, но встречаем каждый день
Level One
Мария Мамкаева
Каждый день мы сталкиваемся с десятками тысяч микробов. Одни обучают нашу иммунную систему и делают колбасу салями, другие выделяют сильнейшие токсины, замораживают воду и портят бабушкин компот. На лекции мы поговорим о микробиологии: разберемся, что она изучает и какими методами, узнаем историю науки и последние открытия. Сделаем акцент на бактериях — выясним, какими они бывают, что умеют делать и почему стоит научиться любить бактерии, живущие внутри нас.
Для просмотра содержимого вам необходимо зарегистрироваться!Для просмотра содержимого вам необходимо зарегистрироваться!
Последнее редактирование модератором:
- Статус
- В этой теме нельзя размещать новые ответы.
